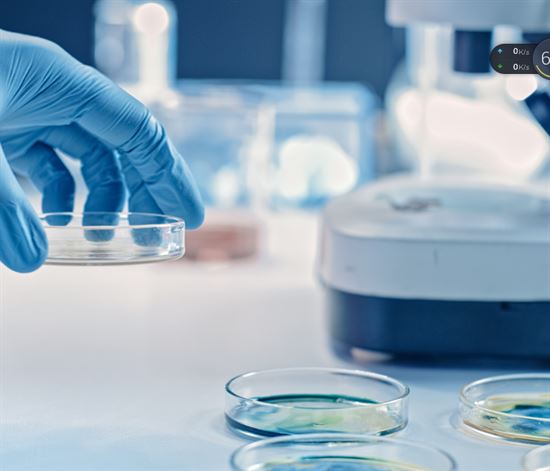

近日,有外媒報道,雅馬哈汽車公司在美國特拉華州成立了一家名為Tuning Fork Bio(音叉生物)的醫療器械企業。該公司將采用抗體分析服務,通過測試和分析人體內的抗體,協助供應商預防疾病,并在必要時確定適當的治療方案。

據了解,雅馬哈是一家來自日本的傳奇性公司,公司創立于1887年,在一百多年發展歷程里,該公司完成了多次跨界,一度被打上了“不務正業”/“無所不能”等標簽。此次,雅馬哈又將把手伸入醫療器械領域,所成立的Tuning Fork Bio公司將主要在美國和日本開展業務,并與福島醫科大學的轉化研究中心(TR中心)達成合作。
01“不務正業”的巨頭布局醫療器械
作為世界知名的的綜合性集團,雅馬哈的“不務正業”源于其創始人山葉寅楠,原本是一名醫療器械的修理工,卻因為修風琴,在1887年創建了雅馬哈公司,從樂器起家,開啟了一個同屬于各行業的偉大時代。
在一百多年的發展歷程里,雅馬哈傳承了創始人山葉寅楠的“不務正業”,完成了多次跨界,不但在起家的樂器行業樂器行業做到世界頂尖,更是在一些毫無聯系的行業創造出屬于自己的傳奇,涉及樂器、飛機螺旋槳、浴缸、泳池、高爾夫球桿、發動機引擎、摩托艇、生化研究、度假村等多個行業。
此次其又選擇進入醫療器械領域,在美國特拉華州成立了Tuning Fork Bio(音叉生物),該公司將利用Cell Handler平臺,這是一個于2017年推出的細胞拾取和成像系統,通過以手動難以實現的速度選擇甚至不到一毫米大小的細胞,簡化細胞培養過程。

同時使用抗體分析技術和專業知識,選擇針對特定疾病的抗體(一種蛋白質)并與患者自身的抗體進行比較,以分析他們當前的健康狀況,即抗體譜。這些信息將為醫療機構進行的健康檢查帶來好處,有助于為患者選擇最佳藥物,有助于制藥公司的新藥研究。
目前該公司主要在美國和日本市場開展業務;并已與福島醫科大學的轉化研究中心(以下簡稱“TR中心”)達成合作開展業務。TR中心利用將蛋白質高密度轉移到載玻片上的技術開發了蛋白質微陣列(超過10000種)。通過測量微陣列上的蛋白質(抗原)與血液中的抗體的結合狀態,可以全面地搜索個體體內的抗體。TR中心準備的蛋白質樣本總數超過20000種,是世界上最多的(根據雅馬哈汽車研究),不僅包括人類蛋白質,還包括來自病毒和細菌的蛋白質。

在合作中,Tuning Fork Bio使用專有的生物信息學技術分析蛋白質微陣列數據,以選擇適合的用作評估健康狀況、診斷等的指標(即生物標記)的抗體,構建適用于執行診斷的系統。旨在提供診斷服務,通過幫助預防疾病的發作和促進選擇最適合每個人情況的藥物來幫助人們進行更積極的生活規劃。

Tuning Fork Bio首席執行官表示:“展望未來,我們預計世界各地人們的價值觀將變得越來越多樣化,圍繞全球環境和社會的問題將變得更加嚴重和復雜。我們還認為,人工智能的高端進步和向信息社會的過渡將使保持與人類敏感性的協調變得更加重要,”“我們希望對社會的需求作出反應,將我們迄今培養的技術和敏銳的敏感性結合起來,以便更好地與人保持一致,并通過獨特的雅馬哈方法擴大人類的可能性。”
未來將進行更多的投資與合作
該公司還表示,未來將通過尋找更多的生物標志物來努力完善其技術,并通過在日本投資和抗體相關企業,在醫療保健領域開發新業務。根據其2030年的長期愿景“human possibilities(人類可能性的藝術)”,該公司正在進入醫療器械行業。

該公司還指出,隨著業務的發展,它正在尋找與其他公司合作的機會。Tuning Fork Bio表示Tuning Fork Bio公司的優勢在于其作為發現新抗原和抗體的發現引擎的能力。因此,潛在的合作伙伴將是那些已經擁有診斷技術的公司,這將是對雅馬哈業務的補充。
02多家車企布局醫療器械
車企布局醫療器械并不“鮮為人知”,尤其是在疫情期間,全球醫療物資緊缺,國內外多家車企入局,包括特斯拉、本田、勞斯萊斯、比亞迪、五菱等,進入口罩、呼吸機、監護儀等領域。而進入2023年亦有知名車企巨頭進軍醫療器械行業。
比亞迪
包括2023年4月,比亞迪申請注冊了“遠燈醫療”“月呀·醫美”商標,國際分類均為醫療器械。而在次之前其已經多次布局醫療器械領域,旗下比亞迪電子已經有經驗豐富的醫療器械生產經驗及專業的醫療器械開發團隊,研發產品包含I類、II類、III類醫療器械,涉及有源、無源,且已通過ISO13485、QSR820、以及國內GMP等相關體系認證,并取得CE、FDA和國內產品的注冊證。

2022年6月,比亞迪還公布了一項關于超聲骨刀的專利。超聲骨刀作為一種新型的醫療器械,伴隨著各種高頻率的震動,這導致超聲骨刀對制作材料的要求極高。根據《2019年醫療器械藍皮書》的數據,我國超聲骨刀國產化率不足10%,市場份額被進口產品所占據。其中鈦合金的刀頭,以及換能器和超聲發生器中的壓電陶瓷,這些材料都被國外所壟斷。
而比亞迪所公布超聲骨刀的專利顯示,其重新設計了超聲骨刀的換能器,改善了骨刀的握感,還完成了使用陶瓷代替鈦合金刀頭的實驗。
現代汽車
無獨有偶,2023年7月現代汽車公司向Asan醫療中心捐贈了現代汽車的醫療可穿戴機器人“X-ble MEX”,用于患者支持和合作研究。在這之前,現代汽車曾與Asan醫療中心和公民安全聯盟簽署協議,該協議確立了一項為期兩年的承諾,現代汽車將為截癱患者提供兩個可穿戴機器人,支持其康復服務,并利用公司未來的移動設備開展合作研究。

據悉,X-ble MEX是現代機器人實驗室開發的一種可穿戴醫療機器人,也稱醫療外骨骼,用于幫助下肢肌肉重建和關節靈活性恢復。這款可穿戴式機器人對截癱患者尤其有益,可以幫助患者進行各種各樣的運動,比如在平坦的地面上行走、爬樓梯、坐和站立。總重(包含電池)小于18kg,最大行走時速為1.2km每小時。電池可支持85kg的用戶,以0.75km/h的時速持續行走一個半小時。可跨越的最大階梯高度為15~25cm。
該機器人的框架可以調節,以適應不同用戶的身體尺寸,可承擔100kg的負載。扶手處設有緊急按鈕,可在設備故障或發生緊急情況時關停設備,保障用戶安全。

而“X-ble”是現代機器人實驗室推出的用于醫療和工業用途可穿戴機器人的品牌名稱。“X”代表機器人技術的無限潛力,和單詞“able能夠”組合意味著能使任何事情發生。此次推出的‘X-ble MEX’是該陣容中的首款產品,并計劃在未來進一步擴大產品范圍。
03市場潛力巨大
目前體外診斷(IVD)在臨床醫學上使用率極高,它能夠便捷、低成本、低傷害地為醫護人員提供精確、早期的臨床診斷信息,為疾病發現、治療、監測提供有效依據,并能大大節省醫療費用,成為了醫療決策的重要依據。
隨著全球經濟的發展、人們保健意識的提高以及全球多數國家醫療保障政策的完善,全球IVD行業持續發展。2019年全球IVD行業市場規模約為714億美元,年均復合增長率增為5%,并在2020年預測有望達到747億美元。據Grand View Research的統計,2020年由于受到新冠肺炎疫情的影響,實際約為834億美元。
市場主要分布在北美、歐洲、日本等發達經濟體國家,歐美日共占據全球體外診斷行業60%以上的市場份額,需求相對穩定,增長緩慢。中國、印度等新興經濟體國家全球市場份額占比較低,但由于人口基數大、經濟增速高,近幾年醫療保障投入和人均醫療消費支出持續增長,體外診斷行業正處于快速增長期,2020年中國市場規模已超過800億元,并持續保持雙位數增長趨勢。
體外診斷按檢測原理或檢測方法,可以分為生化診斷、免疫診斷、分子診斷、微生物診斷、血液診斷等。
隨著疫情逐漸得到控制,體外診斷行業也開始進行整合。雅馬哈汽車公司選擇了進軍IVD領域,成立了名為Tuning Fork Bio(音叉生物)的醫療器械企業,目標市場達到了千億級別。目前,該公司已經與TR中心開展了一項涉及世界上蛋白質樣本總數最多的合作研究,起步便朝著行業巔峰邁進。此外,該公司還計劃在未來進行更多的投資,并期待與行業領先企業合作。鑒于雅馬哈在過往的卓越表現,我們對其未來在IVD行業的發展充滿了期待。我們將繼續關注其在該領域的動態,期待其帶給我們更多的驚喜。
